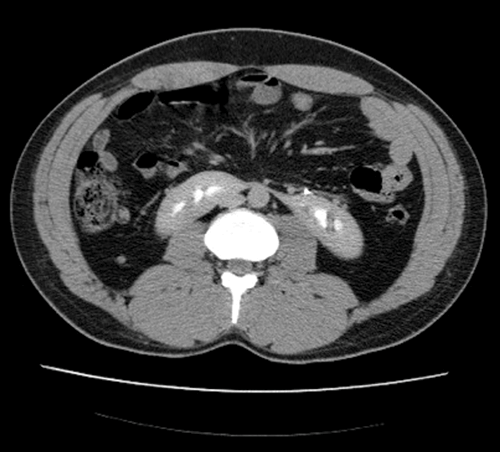

Case 1
1. What is the abnormality and how common is it?
2. What is the embryological origin?
3. With what other conditions can this be associated?
Case 2

1. What is the diagnosis and how common is it?
2. What is its embryological origin?
3. Which side is the fused renal unit commonly found?
Case 3

1. What is the anatomical abnormality demonstrated?
2. How common is this abnormality and how is it classified?
3. Which ureter drains where, and why?
4. What are the potential associated findings with this abnormality?
Case 4

1. What is the anatomical abnormality demonstrated on this computed tomography (CT) urogram?
2. How can it be classified?
3. What common abnormality is associated with this?
Upper Tract Developmental Abnormalities - Answers
Case 1
-
CT urogram demonstrates contrast in both collecting systems and fused kidney inferiorly, consistent with a horseshoe kidney; one case in 400.
-
Fusion of the metanephric masses, usually at the lower pole. Inferior mesenteric artery obstructs ascent of the isthmus, leaving the isthmus at level of L3/4.
-
Pelviureteric junction (PUJ) obstruction (approximately 33%), stones (20%), undescended testes, hypospadias and Turner’s syndrome.
Case 2
-
Plain coronal CT kidney, ureter, bladder (KUB) demonstrating crossed fusion renal ectopia; one case in 1000.
-
Theories include: a. abnormally situated umbilical artery preventing normal cephalic migration. b. the ureteric bud crosses to the opposite side inducing nephron formation in the contralateral metanephric blastema.
-
Left to right ectopy is more common (3:1).
Case 3
-
Left duplex kidney / collecting system.
-
One case in 125. Incomplete - common, rarely clinically significant. Complete - rare, often clinically significant.
-
The Weigert-Meyer law states the upper pole moiety ureter drains infero-medial to the normal lower moiety ureter.
-
Ureterocoele, reflux in the lower moiety, obstruction in the upper moiety (usually due to ureterocoele), PUJ obstruction, ectopic ureters.
Case 4
-
Right sided ureterocoele, with a normal upper tract.
-
Simple (intravesical) 25% or ectopic 75%.
-
Majority of ectopic ureterocoeles are associated with a duplex collecting system.

